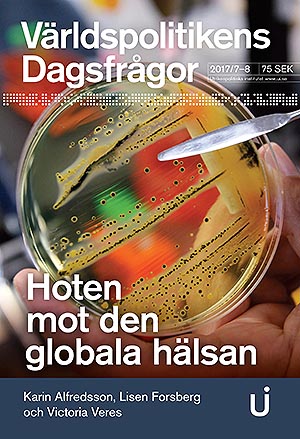
Hoten mot den globala hälsan

Balkan: Vinglig färd mot väst
Denna skrift handlar om utvecklingen på västra Balkan, dvs Albanien, Bosnien-Hercegovina, Kosovo, Kroatien, Makedonien, Montenegro och Serbien, sedan krigen på 1990-talet.
Författaren Jessica Giandomenico beskriver också spänningarna mellan EU, som försöker bevara stabiliteten i regionen, och Ryssland som vill öka sitt inflytande och framför allt förhindra Natos expansion i området.
Nr 9 2017, Författare: Jessica Giandomenico
Tips till lärare
Instuderingsfrågor i PDF och Seminarium: Geopolitik och instabilitet i EU:s närområde